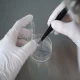
Thủy Sản An Toàn: Nâng Cao Ý Thức và Thực Hành Kiểm Soát Dư Lượng Hóa Chất

Bảo Vệ Mang Tôm: Giải Pháp Đối Phó Với Vấn Đề Vật Chất Lơ Lửng Trong Nuôi Trồng Thủy Sản
Tôm là một trong những loài thủy sản quan trọng trong ngành nuôi trồng thủy sản, đóng góp lớn vào nền kinh tế và đời sống người dân. Tuy nhiên, trong quá trình nuôi tôm, một trong những vấn đề nghiêm trọng mà người nuôi phải đối mặt là tình trạng các vật chất lơ lửng bám vào mang tôm. Các vật chất này có thể gây ảnh hưởng tiêu cực đến sức khỏe và sự phát triển của tôm. Bài viết này sẽ phân tích nguyên nhân, hệ quả của việc bám dính các vật chất lơ lửng lên mang tôm và đưa ra các giải pháp để khắc phục tình trạng này.
Hiểu về mang tôm
Cấu tạo và chức năng của mang tôm
Mang tôm là cơ quan hô hấp chính, có chức năng trao đổi khí, giúp tôm hấp thụ oxy và thải ra carbon dioxide. Cấu tạo của mang tôm bao gồm nhiều phiến mang, được sắp xếp thành các lớp, giữa các lớp là không gian để nước có thể chảy qua. Nhờ cấu trúc này, mang tôm có thể hoạt động hiệu quả trong việc hấp thụ oxy từ nước và đảm bảo cho quá trình hô hấp.
Tầm quan trọng của mang tôm trong nuôi trồng thủy sản
Mang tôm không chỉ đảm nhiệm chức năng hô hấp mà còn đóng vai trò quan trọng trong việc bảo vệ tôm khỏi các tác nhân gây bệnh. Sức khỏe của mang tôm có ảnh hưởng trực tiếp đến sức khỏe tổng thể của tôm, do đó việc chăm sóc và bảo vệ mang tôm là rất cần thiết.
Các vật chất lơ lửng bám vào mang tôm
Khái niệm về vật chất lơ lửng
Vật chất lơ lửng là các hạt rắn hoặc lỏng có kích thước nhỏ, không hòa tan trong nước, tồn tại dưới dạng các hạt nổi trên bề mặt nước hoặc lơ lửng trong nước. Các vật chất này có thể xuất phát từ nhiều nguồn khác nhau như nước thải, thức ăn thừa, chất thải từ tôm, hoặc từ môi trường.
Các loại vật chất lơ lửng phổ biến trong ao nuôi tôm
- Hạt cát và đất : Những hạt nhỏ từ đáy ao hoặc từ các hoạt động khai thác đất, cát có thể dễ dàng hòa trộn vào nước và bám vào mang tôm.
- Chất hữu cơ phân hủy : Thức ăn thừa và chất thải từ tôm có thể phân hủy và tạo ra các hạt lơ lửng.
- Vi khuẩn và tảo : Một số loại vi khuẩn và tảo cũng có thể bám vào mang tôm, gây cản trở quá trình hô hấp.
Nguyên nhân hình thành các vật chất lơ lửng
- Môi trường nuôi trồng không đảm bảo : Nguồn nước ô nhiễm hoặc không được xử lý đúng cách là nguyên nhân chính dẫn đến sự hình thành vật chất lơ lửng trong ao.
- Quản lý thức ăn không hợp lý : Sử dụng thức ăn không chất lượng hoặc cho ăn quá mức có thể dẫn đến sự tích tụ thức ăn thừa, tạo điều kiện cho sự hình thành hạt lơ lửng.
- Quá trình phân hủy chất thải : Chất thải từ tôm và vi sinh vật có thể gây ra tình trạng phân hủy trong nước, tạo ra các hạt lơ lửng.
Hệ quả của việc các vật chất lơ lửng bám vào mang tôm
Ảnh hưởng đến hô hấp của tôm
- Cản trở việc trao đổi khí : Các vật chất lơ lửng bám vào mang tôm sẽ làm giảm khả năng hấp thụ oxy, gây khó khăn trong quá trình hô hấp. Tôm có thể bị thiếu oxy, dẫn đến tình trạng stress và tăng nguy cơ chết.
- Tăng nguy cơ mắc bệnh : Khi mang tôm bị bám bẩn, vi khuẩn và vi rút có thể xâm nhập dễ dàng hơn, tăng nguy cơ nhiễm bệnh. Các bệnh lý về mang như viêm mang hay nhiễm trùng có thể xảy ra.
Giảm sức khỏe và tăng trưởng của tôm
- Giảm khả năng tăng trưởng : Tôm không được cung cấp đủ oxy sẽ chậm lớn và không phát triển bình thường. Điều này ảnh hưởng đến năng suất nuôi trồng và lợi nhuận.
- Suy giảm sức đề kháng : Việc mang tôm bị ô nhiễm có thể làm giảm sức đề kháng của chúng đối với các tác nhân gây hại khác, làm tăng nguy cơ chết hàng loạt.
Tác động đến chất lượng sản phẩm
- Giảm chất lượng tôm : Tôm bị ảnh hưởng bởi các vật chất lơ lửng có thể không đạt tiêu chuẩn chất lượng, ảnh hưởng đến giá trị thương phẩm.
- Khó khăn trong chế biến : Tôm có mang bẩn hoặc bị bệnh sẽ khó chế biến và tiêu thụ hơn, dẫn đến thất thoát kinh tế cho người nuôi.
Giải pháp khắc phục tình trạng vật chất lơ lửng bám vào mang tôm
Cải thiện chất lượng nước
- Xử lý nước trước khi thả tôm : Nguồn nước cần được xử lý và kiểm tra chất lượng trước khi đưa vào ao nuôi. Các phương pháp như lọc nước, xử lý hóa học có thể giúp loại bỏ vật chất lơ lửng.
- Theo dõi chất lượng nước định kỳ : Cần thường xuyên kiểm tra các chỉ tiêu về pH, độ trong, nồng độ oxy, và các chất ô nhiễm khác để đảm bảo môi trường sống của tôm luôn được duy trì ở mức an toàn.
Quản lý thức ăn hợp lý
- Chọn thức ăn chất lượng : Sử dụng thức ăn có chất lượng tốt, phù hợp với từng giai đoạn phát triển của tôm để giảm thiểu thức ăn thừa.
- Điều chỉnh lượng thức ăn : Cần cho tôm ăn đúng lượng cần thiết, tránh tình trạng dư thừa thức ăn trong ao.
Thực hiện các biện pháp vệ sinh ao nuôi
- Thay nước định kỳ : Việc thay nước thường xuyên giúp loại bỏ vật chất lơ lửng và chất thải trong ao, duy trì môi trường nước sạch cho tôm.
- Vệ sinh ao và dụng cụ nuôi : Các dụng cụ nuôi và ao cũng cần được vệ sinh định kỳ để giảm thiểu sự tích tụ của vật chất bẩn.
Sử dụng các biện pháp sinh học
- Sử dụng vi sinh vật có lợi : Các loại vi sinh vật có lợi có thể được đưa vào ao để cạnh tranh với vi khuẩn gây hại, giảm thiểu sự phát triển của vật chất lơ lửng.
- Áp dụng công nghệ aquaponics : Hệ thống aquaponics có thể giúp duy trì chất lượng nước tốt hơn và giảm thiểu sự bám dính của vật chất lơ lửng.
Giáo dục và nâng cao nhận thức cho người nuôi
- Tổ chức các lớp đào tạo : Cần tổ chức các lớp đào tạo cho người nuôi tôm về cách quản lý ao nuôi và chăm sóc sức khỏe cho tôm.
- Cung cấp tài liệu hướng dẫn : Cung cấp tài liệu hướng dẫn về các phương pháp nuôi tôm bền vững và an toàn cho sức khỏe tôm.
Kết luận
Các vật chất lơ lửng bám vào mang tôm là một vấn đề nghiêm trọng trong nuôi trồng thủy sản, ảnh hưởng đến sức khỏe và sự phát triển của tôm. Để khắc phục tình trạng này, cần có sự kết hợp giữa các biện pháp cải thiện chất lượng nước, quản lý thức ăn hợp lý, thực hiện vệ sinh ao nuôi, áp dụng công nghệ và nâng cao nhận thức cho người nuôi. Chỉ khi giải quyết triệt để các vấn đề này, ngành nuôi tôm mới có thể phát triển bền vững và đảm bảo năng suất cao.